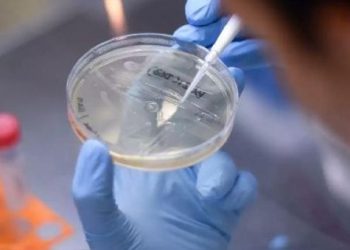

Detectan en la República Dominicana la variante delta
Santo Domingo, 16 sep (EFE).- Las autoridades sanitarias de República Dominicana confirmaron este jueves la presencia en el país de la variante delta del SARS-CoV-2, que provoca el coronavirus (COVID-19), ...